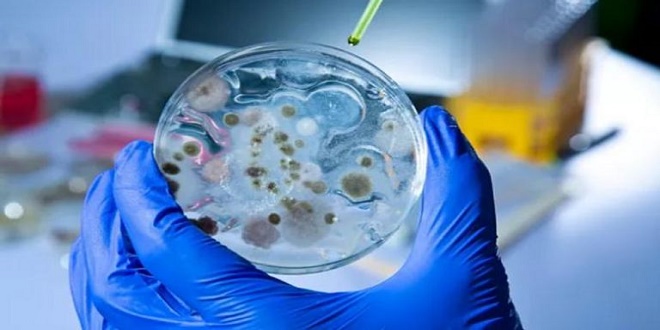

شام تايمز – متابعة
كشفت دراسة علمية حديثة أن الكائنات المجهرية في التربة، ولا سيما الفطريات والبكتيريا، تلعب دوراً غير مباشر بتشكيل الأمطار، في اكتشاف يفتح آفاقاً جديدة لفهم العلاقة المعقدة بين الحياة والأنظمة المناخية.
ووفقاً للدورية العلمية الأمريكية “Science Advances”، والتي أعدها الدكتور “أنطونيو جوفي” من جامعة كاليفورنيا في بيركلي، فإن بعض الكائنات الدقيقة تفرز بروتينات خاصة تسهم في تحفيز تكوّن الهطولات المطرية عبر آليات طبيعية لم تكن معروفة سابقاً.
وأوضحت النتائج أن فطريات من نوع “مورتيريلا” تنتج بروتينات تُعرف باسم “نواة الجليد”، حيث تعمل هذه البروتينات عند انتقالها عبر الرياح إلى طبقات السحب على تسهيل تكوّن قطرات المطر، بما يسهم في بدء عملية الهطول.
وبيّنت الدراسة أن هذه البروتينات تمتاز بقدرتها على البقاء لفترات طويلة حتى بعد موت الفطريات، إضافةً إلى قابليتها العالية للانتقال عبر الغلاف الجوي، ما يجعلها جزءاً فاعلاً في دورة الهطول الطبيعي.
كما أشار الباحثون إلى إمكانية الاستفادة من هذه البروتينات مستقبلاً في تطوير أساليب صديقة للبيئة لتحفيز الأمطار، بدلاً من التقنيات الكيميائية المستخدمة حالياً في استمطار السحب.
وحذّرت الدراسة في الوقت نفسه من أن تراجع الغطاء النباتي، وإزالة الغابات قد يؤثر في هذه العمليات الحيوية الدقيقة، ما ينعكس سلباً على انتظام الهطولات المطرية في بعض المناطق.
وتفتح هذه الدراسة مجالاً واسعاً لإعادة فهم التفاعلات الدقيقة بين الكائنات المجهرية والغلاف الجوي، ودورها المحتمل في تنظيم الأنماط المناخية، بما قد يسهم مستقبلاً في تطوير حلول طبيعية ومستدامة لتحفيز الهطول المطري.
 شام تايمز الإخباري رؤية لسورية أجمل
شام تايمز الإخباري رؤية لسورية أجمل